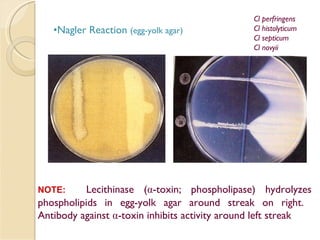
Nagler Reaction  (egg-yolk agar) NOTE:   Lecithinase ( α -toxin; phospholipase) hydrolyzes phospholipids in egg-yolk agar around streak on right.  Antibody against  α -toxin inhibits activity around left streak Cl perfringens Cl histolyticum Cl septicum Cl novyii

The document discusses several Clostridium species including C. perfringens, C. botulinum, C. tetani. It covers their characteristics, virulence factors, diseases caused like gas gangrene, food poisoning, botulism. Management includes prompt surgery, antitoxins, antibiotics for C. perfringens. C. botulinum toxin blocks acetylcholine release causing flaccid paralysis. Its toxin is neutralized by antitoxin.